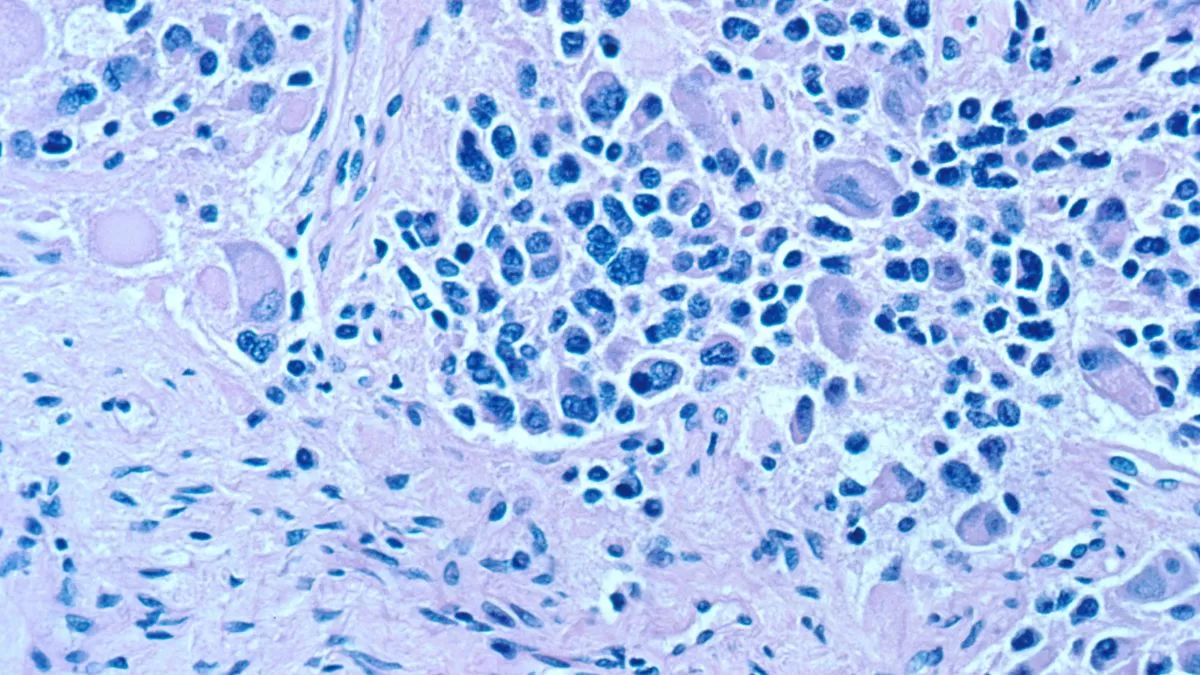
Cáncer

El zika es un virus que pueden transmitir los mosquitos. Se identificó por primera vez en un macaco Rhesus en Uganda durante 1947 y, en la década del 50, se encontró evidencia en otros países de África de que esta infección viral también podía hallarse en seres humanos.
En décadas posteriores se encontraron casos también en otros continentes, y ya en 2007 se registraron brotes tanto en África como en en Asia y también en las Américas, según la Organización Mundial de la Salud.
Hoy, un estudio intenta demostrar que este virus podría tener un positivo uso en pos de mejorar la salud humana.
El zika versus tejidos cancerosos
A través de un estudio publicado en el repositorio Cancer Research Communications, los investigadores usaron el virus para probarlo en ratones. Se les implantaron células de neuroblastomas humanos.
En esta enfermedad, se forman células cancerosas en tejidos nerviosos inmaduros (neuroblastos) y que pueden formarse en el cuello, en las glándulas suprarrenales o incluso en la médula espinal, según detallan en el National Cancer Institute.
De acuerdo con los resultados de la investigación, se demostró que el zika tenía un efecto rápido al matar tumores.
Poco después de la inyección, se detectó que la proteína viral NS1 estaba dentro del tumor junto con una gran cantidad de copias virales. Ello condujo a un incremento importante en el tejido necrótico del tumor, al mismo tiempo que una disminución de su masa, según se lee en el estudio.
Así, a partir de la inyección del virus en estos ratones, los tumores formados mostraron inmediatamente una muerte casi completa de los tejidos cancerosos. Además, el experimento arrojó que estos animales de prueba tuvieron una supervivencia prolongada.
Joseph Mazar, primer autor del estudio, comentó a Live Science que se trató de "una diferencia impresionante". "Conseguimos de un 80 a un 90% de eficacia. Los tumores fueron erradicados, con una sola inyección, sin recurrencia y sin síntomas".
Sigue a Rockandpop.cl en Google Discover
Recibe nuestros contenidos directamente en tu feed.